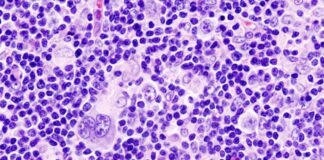
Major Improvements In Treating Hodgkin’s Lymphoma

Celebrity Thriver: Yuvraj Singh (Lung Cancer)
Cricketer Yuvraj Singh's cancer journey was covered extensively in the media. Yuvi's openness on social media also lead him to receive an enormous amount of support from his fans and well-wishers.
Wit: Movie Review
Wit is a movie about a woman's journey with ovarian cancer. Dr. Vivian Bearing, played by Emma Thompson, finally realises the importance of human connection and empathy through her cancer.
Audacity of Hope: Breast Cancer Thriver With An Iron Will (1...
When facing a difficult cancer journey, the best way to remain hopeful is to read real examples of courageous people (like Rupa) who have experienced and overcome their illness. We bring you Part 1 of her inspiring story.
Healing and the Mind – Wounded Healers (6 of 6)
In the final instalment of the series, Bill Moyers gives us an inside view of a successful holistic and integrated program for cancer patients.
Major Improvements In Treating Hodgkin’s Lymphoma
Now, Hodgkin lymphoma is considered one of the most curable cancers due to rapid and successful advancements in treatments and diagnosis.
Healing and the Mind: By Bill Moyers – The Mystery Of...
Will we continue writing off every approach to treatment other than Western medicine when it could possibly give us a fighting chance at a longer and healthier life?